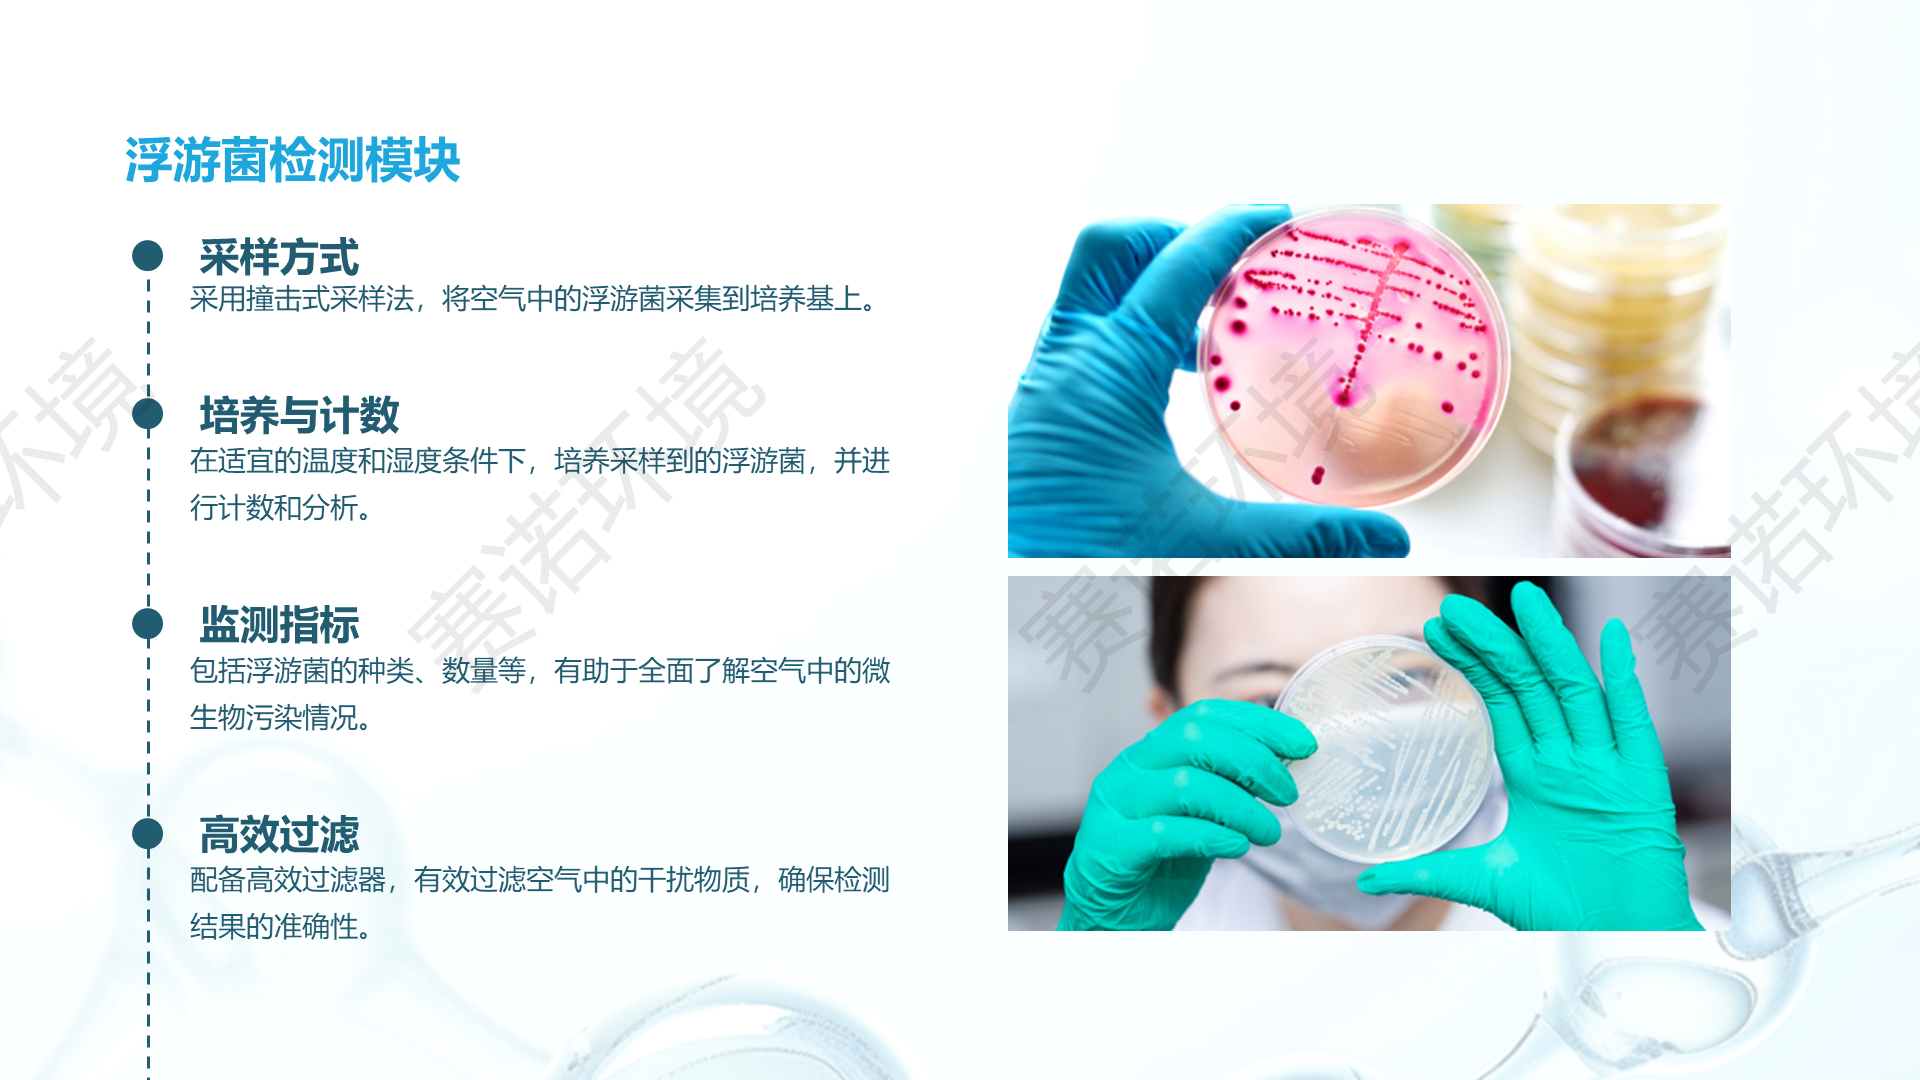

制药、医疗、生物科技等行业
Products
- 首页
-
产品中心
-
洁净检测仪器
- SN-810系列尘埃粒子计数器(100L)
- SN-510系列尘埃粒子计数器(0.3/大流量)
- SN-310型尘埃粒子计数器(手持式)
- SN-210型尘埃粒子计数器(0.1/大流量)
- SN-110型尘埃粒子计数器(0.1)
- SN-5106SX型表面尘埃粒子计数器
- SN-004型尘埃粒子计数器校准装置
- SN-003型空气浮游菌采样器(三档采样量)
- SN-002型空气浮游菌采样器(双流量)
- SN-001型空气浮游菌采样器
- SN-G10型气溶胶光度计
- SN-Q3型气溶胶发生器(便携式/冷发)
- SN-Q2型气溶胶发生器(热发)
- SN-Q1型气溶胶发生器(冷发)
- SN-HPD02型高压扩散器
- SN-HPD01型高压扩散器
- SN-005型气溶胶稀释器
- SN-620型气流流形测试仪
- SN-FLY-2风量仪
- SN-8500型便携式生物气溶胶监测仪
-
净化设备
- SN-BSC A2系列生物安全柜
- SN-BSC B2系列生物安全柜
- SN-CJ-2D双人单面垂直层流洁净工作台(全钢智能型)
- SN-CJ-1D单人单面垂直层流净化工作台(实用型)
- SN-CD系列传递窗
- SN-VHP-1000灭菌传递窗
- SN-FL系列风淋室
- SN-JJ系列洁净棚
- SN-CL系列负压称量罩
- SN-LC系列层流罩
- SN-CC系列洁净层流车
- SN-GL高效过滤器
- SN-MERV系列中效袋式空气过滤器
- SN-MERV系列组合式中效空气过滤器
- SN-FFU风机过滤单元
- SN-HEPA系列液槽密封高效空气过滤器
- SN-HH系列耐高湿高效空气过滤器
- SN-HEPA系列有隔板高效空气过滤器
- SN-PTFE无隔板高效空气过滤器
- SN-ULPA系列超高效无隔板空气过滤器
-
实时智能监测
- 赛诺环境在线粒子监控系统
- SN-F002型在线浮游菌采样器(无屏)
- SN-F001型在线浮游菌采样器(无屏)
- 28.3L在线尘埃粒子计数器SN-CW5100S(0.1μm)
- 28.3L在线尘埃粒子计数器SN-CW3100M
- 2.83L在线尘埃粒子计数器SN-CW1100P
- 28.3L在线尘埃粒子计数器SN-CW3100G
- 2.83L在线尘埃粒子计数器SN-CW1100X
- 28.3L在线尘埃粒子计数器SN-CW2100
- 2.83L在线尘埃粒子计数器SN-CW1100M
- 28.3L在线尘埃粒子计数器SN-CW2100S
- 2.83L在线尘埃粒子计数器SN-CW1100S
- 0.1μm在线尘埃粒子计数器SN-CW1100H/2100H
- SN-RT系列无尘室多功能环境监测机器人
- SN-002型空气浮游菌采样器(双流量)
- ESD仪器
-
洁净检测仪器
- 增值服务
- 解决方案
- 关于我们